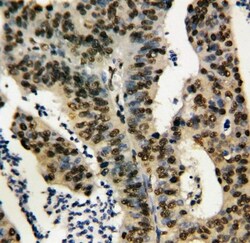
Invitrogen TNFAIP1 Polyclonal Antibody 100 &mu;g; Unconjugated:Antibodies,

Learn More
Invitrogen™ TNFAIP1 Polyclonal Antibody


Rabbit Polyclonal Antibody
Brand: Invitrogen™ PA580141
Description
Reconstitute with 0.2 mL of distilled water to yield a concentration of 500 μg/mL. Positive Control - WB: human Hela whole cell, human HEK293 whole cell, mouse HEPA1-6 whole cell. IHC: human rectal cancer tissue, rat pancreas tissue, mouse pancreas tissue, human pancreas cancer tissue. ICC/IF: Hela cell.
This gene was identified as a gene whose expression can be induced by the tumor necrosis factor alpha (TNF) in umbilical vein endothelial cells. Studies of a similar gene in mouse suggest that the expression of this gene is developmentally regulated in a tissue-specific manner.
Specifications
| TNFAIP1 | |
| Polyclonal | |
| Unconjugated | |
| TNFAIP1 | |
| B12; B61; BACURD2; BTB/POZ domain-containing adapter for CUL3-mediated RhoA degradation protein 2; BTB/POZ domain-containing protein TNFAIP1; BTBD34; EDP1; Edp-1; hBACURD2; Protein B12; TNF alpha induced protein 1; Tnfaip1; Tnfip1; tumor necrosis factor induced protein 1; tumor necrosis factor, alpha induced protein 1; tumor necrosis factor, alpha-induced protein 1 (endothelial); Tumor necrosis factor, alpha-induced protein 1, endothelial; Tumor necrosis factor-induced protein 1 | |
| Rabbit | |
| Antigen affinity chromatography | |
| RUO | |
| 21927, 287543, 7126 | |
| -20°C | |
| Lyophilized |
| Immunohistochemistry (Frozen), Immunohistochemistry (Paraffin), Western Blot, Immunocytochemistry | |
| 500 μg/mL | |
| PBS with 5mg BSA and 0.05mg sodium azide, 0.05mg thimerosal | |
| O70479, Q13829, Q7TNY1 | |
| TNFAIP1 | |
| A synthetic peptide corresponding to a sequence at the N-terminus of human TNFAIP1 (27-52aa NKYVQLNVGGSLYYTTVRALTRHDTM). | |
| 100 μg | |
| Primary | |
| Human, Mouse, Rat | |
| Antibody | |
| IgG |
Your input is important to us. Please complete this form to provide feedback related to the content on this product.